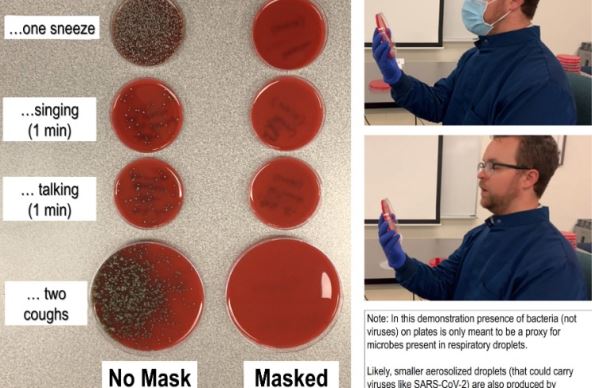

Iako lekari i naučnici konstantno upozoravaju na nošenje zaštitne maske u javnosti kako bi se smanjilo širenjekorona virusa, mnogi još uvek veruju da ih to ne može zaštititi.
Mikrobiolog Ričard Dejvis je zbog toga izveo eksperiment i rezultatima zapanjio sve. Na Twitteru je objavio fotografije eksperimenta i dokazao koliko maske za lice i socijalna distanca smanjuju širenje zaraze.
U eksperimentu je koristio Petrijeve šolje napunjene agarima, želatinoznom supstancom dobijenom od crvene alge koja pomaže razmnožavanju mikroorganizama. Nakon obavljanja svake radnje, Dejvis je rekao kako su se u posudama na koje su spuštale respiratorne kapljice iz njegovih usta slivale kolonije bakterija.
U prvom eksperimentu prikupio je bakterije pevanjem, pričanjem, kijanjem i kašljanjem, sa maskom i bez nje. Pokazao je da se bakterije, dok je nosio masku, nisu gotovo uopšte širile, dok je bez maske rezultat zastrašujući.
Zatim je testirao koliko nas štiti fizičko distanciranje, takođe s maskom i bez nje. Kašljao je s tri različite udaljenosti – pola metra, 1,2 i malo manje od dva metra. Tako se pokazalo da razmak od pola metra, dok se ne nosi maska, ništa ne pomaže, dok je onaj od dva zaista siguran. S nošenjem maske, potvrdio je, nije važna udaljenost jer se bakterije ne šire.
Kašljao je, kijao, pevao i pričao kroz masku i bez nje


